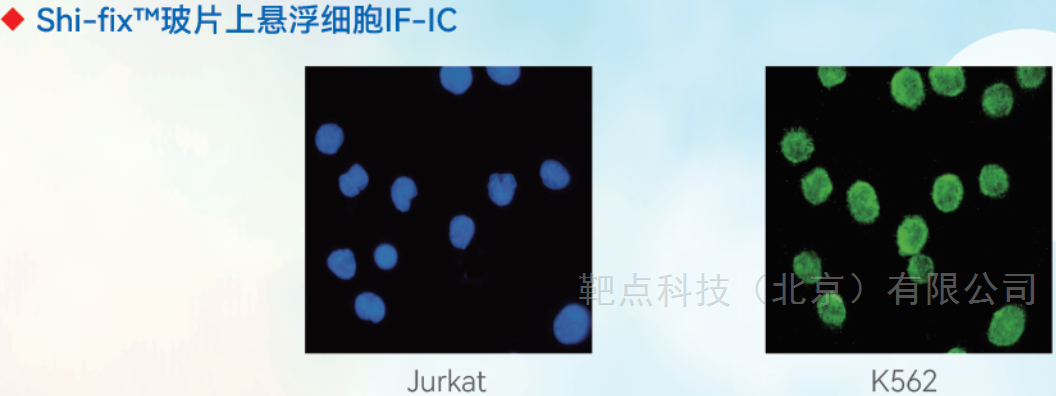
悬浮细胞免疫荧光专用玻片使用解决方案文献参考
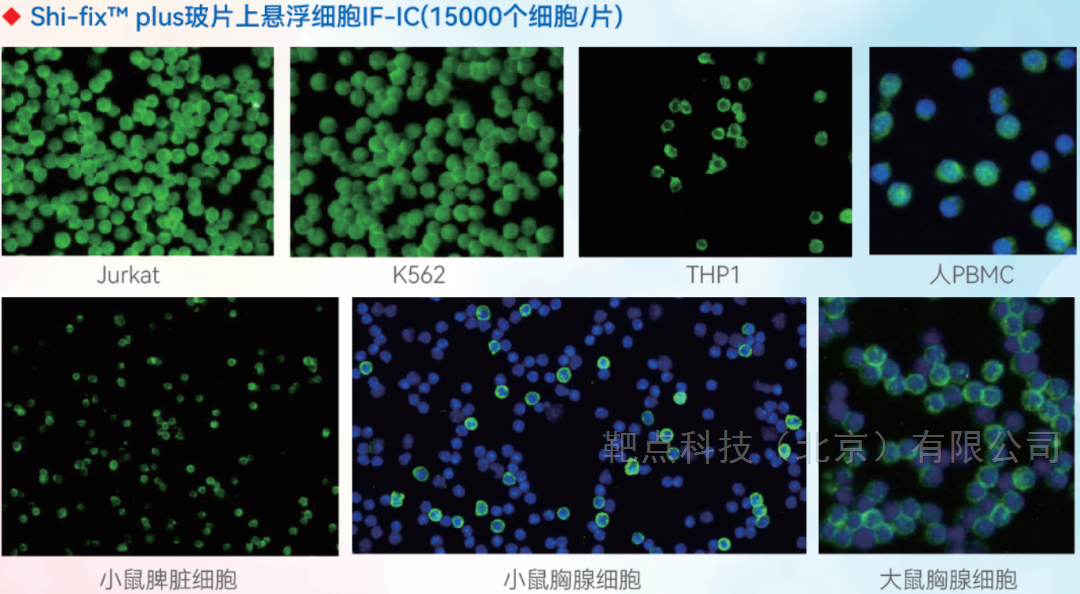
悬浮细胞免疫荧光专用玻片使用解决方案文献参考

7 年
手机商铺
新闻中心/正文
370 人阅读发布时间:2024-12-15 17:28
悬浮细胞免疫荧光的挑战
免疫荧光(IF)技术基于抗原-抗体反应的原理,利用荧光标记抗体检测和定位细胞或组织中的特定抗原。细胞免疫荧光(IF-IC)以细胞为样本、细胞需牢固地生长/附着在玻片上,防止细胞在后续清洗、固定、破膜和染色时丢失。贴壁细胞能粘附生长在包被玻片上,满足IF-IC所需结合力;但悬浮细胞不具备粘附固体表面能力,传统离心甩片或涂片法制备的细胞片存在细胞分布不均、固定不牢导致后续细胞丢失的问题,影响后续染色和显微观察。靶点科技悬浮细胞免疫荧光专用玻片,作为这一痛点的解决方案,可以像贴壁细胞一样处理悬浮细胞。

Shi-fix™玻片
解决悬浮细胞免疫荧光中的难题
悬浮细胞免疫荧光专用Shi-fix™玻片,可牢固地吸附悬浮细胞、后续可像“贴壁细胞”一样完成IF-IC,在获得更好结果的同时,能显著简化实验流程、提高实验效率,同时还节省经费。
Shi-fix™plus玻片
满足低细胞量的悬浮细胞免疫荧光需求
在实际应用中,或许会遇到细胞数量少的特殊样本,运用Shi-fix™玻片可能达不到理想的IF-IC效果。为此Shikhar Biotech在Shi-fix™玻片基础上升级出增强型Shi-fix™ plus玻片(具有更强的悬浮细胞吸附性),解决低数量悬浮细胞样本的IF-IC烦恼!同时,plus适合培养,为刺激实验提供了选择。
使用Shi-fix™玻片发表的文献有哪些?用Shi-fix™玻片做了哪些实验?
1.在Google Patents的Method of treatment上发表的Therapeutic and prophylactic applications of cell penetrating, anti-DNA binding proteins, in particular in the context of inflammatory disease and complications (International Patent WO2023034778A1)中,涉及细胞穿透性抗DNA结合蛋白的治疗和预防应用,特别是在炎症性疾病及其并发症方面的应用,申请者使用Shi-fix™玻片培养PLB-985细胞使其贴壁,进行碱性磷酸酶和DAPI染色。

2.Chang等人开发出一种IL-10结合区的20个氨基酸的多肽(NK20a),它对B细胞淋巴瘤具有抗肿瘤作用,并能消除IL-10对巨噬细胞的抑制作用。进一步将NK20a与纳米金颗粒(负载化疗药物5-FU)偶联,增强了5-FU对乳腺癌细胞株BT-474的抗肿瘤效应。

作者在其中借助Shi-fix™玻片验证了NK20a与纳米金颗粒(负载化疗药物5-FU)偶联物在B细胞中药物递送的可行性,细胞核(DAPI,蓝色)、细胞膜(Cytopainter,红色)、FITC(NK20a, 绿色)。

3.Portelinha等人报告了一种Polo-like激酶4与BCL-2抑制剂的治疗组合,它能引发侵袭性淋巴瘤的基因组不稳定性和细胞死亡。

其中,作者先用Shi-fix™玻片吸附OCI-Ly19细胞,然后免疫荧光染色,验证不同剂量CFI对细胞中心体数量的影响。细胞核(DAPI,蓝色)、pericentrin(红色)、CEP110(绿色)。

作者后续又用Shi-fix™玻片吸附HBL-1细胞,免疫荧光染色验证CFI或Ven及联合对细胞中心体的影响。细胞核(DAPI,蓝色)、pericentrin(红色)。
4.Chen等人评估干扰DDR的核穿透性抗DNA自身抗体对活化的人粒细胞样分化PLB-985细胞和从C57BL/6小鼠中分离出来的中性粒细胞解聚、释放DNA和NETs的影响。
作者用Shi-fix™玻片吸附PLB-985细胞验证DX1的穿透性(AP酶显色系统)。
后续用DAPI(蓝色)和SYTOX Green(绿色)染色吸附于Shi-fix™玻片上的PLB-985细胞,发现DX1可抑制PMA刺激分化PLB-985细胞的染色质解聚和DNA释放。

5.Yao等人研究证实人胃癌组织中NK细胞水平与CAFs数量成反比,CAFs通过诱导铁死亡(铁依赖性脂质过氧化物积累)损害NK的抗肿瘤能力。CAFs通过促进铁超载诱导NK铁死亡,细胞内铁水平降低则能保护NK免受CAFs诱导铁死亡的影响。
作者在研究中借助Shi-fix™玻片对正常pb-NK(外周血NK)和共孵育CAFs的pb-NK染色FerroOrange,判断细胞中“铁池”中铁含量。


6.研究人员将Phe和CHex修饰树枝状聚合物用于T细胞的pH敏感药物递送系统。树枝状聚合物通过内吞被内化到T细胞中,在弱酸(pH 6.5)下,细胞对其摄取能力增强。研究证实Phe和CHex修饰树枝状聚合物具有向T细胞及其亚群递送的潜能,可用于肿瘤免疫疗法。

研究者借助Shi-fix™玻片完成对Jurkat细胞的免疫荧光染色,证实PAMAM-Phe-CHex和 PAMAM-CHex-Phe与CD3-PE染色T细胞相关。细胞核(DAPI,蓝色)、Phe/CHex修饰树枝状聚合物(FITC,绿色)、溶酶体(红色)。
7.在2021年巴塞罗那大学医学院发布的Genetic Disruption of Transfer RNA Modifications in Human Cancer的博士论文中,为使细胞吸附更加牢固,作者借助Shi-fix™玻片完成NCI-H82、DMS-273和HCC-33细胞的免疫荧光染色。

8.Whiteaker等人开发的51重检测方法(DDR-2),可量化蛋白质表达和DNA损伤反应磷酸化。该方法可对永生化淋巴母细胞系和原代人类外周血单核细胞中电离辐射诱导的DNA损伤后的信号转导进行量化,鉴定抑制ATM的PD生物标记物,为临床前和临床研究提供支持。

研究者借助Shi-fix™ coated 96-well microplate先后多次对LCL57细胞进行免疫荧光染色。

9.Kandil等人开发出新型升级版siRNA运送系统(Tf-PEI多聚物),它不仅能通过受体介导的内吞作用将有效载荷特异性运送至所需的靶细胞,还能增强从内泌体囊泡中的释放,从而在细胞质中启动RNAi。

作者在验证Jurkat细胞中siRNA溶酶体释放染色时,用Shi-fix™玻片来固定吸附Jurkat细胞。AF488-siRNA(绿色)、溶酶体(红色)、细胞核(DAPI,蓝色)。

10.论文报道一种合成的标记荧光生长抑素类似物——67/68Ga-MMC(IR800)-TOC,在体内和体外的宏观、中观和微观尺度上都观察到了受体介导的吸收。胰腺NET患者的手术生物样本也显示出受体特异性的药剂结合,可清晰地划分出与病理结果相匹配的肿瘤边界。

在验证细胞对Ga-MMC(IR800)-TOC的结合和内化实验中,作者先用Shi-fix™玻片分别吸附HCT116-SSTR2、NCI-H69和HCT116-WT细胞,与5 µM Ga-MMC(IR800)-TOC(红色)孵育1小时后染色细胞核(绿色),最后用共聚焦显微镜图像。

使用Shi-fix™玻片部分验证细胞结果展示图

靶点科技悬浮细胞免疫荧光专用玻片订购信息
